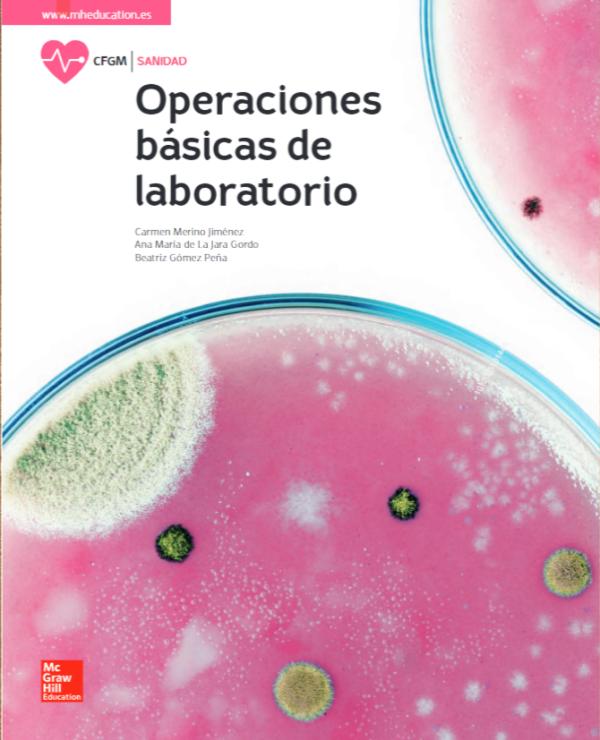

PERO ¿QUÉ HAN HECHO LOS MICROBIOS POR NOSOTROS? 2ED
Fundamentos de Biotecnología Industrial
Manuel Sánchez Angulo
Editorial: García Maroto Editores
Edition: 2
publication date: 2022
ISBN: 9788419299307
ISBN ebook: 9788419299314
pages: 276
Grade: Universitario
Area: Ciencias y Salud
Section: Biología y Ciencias de la Salud
Language: Español
Tweet
Edition: 2
publication date: 2022
ISBN: 9788419299307
ISBN ebook: 9788419299314
pages: 276
Grade: Universitario
Area: Ciencias y Salud
Section: Biología y Ciencias de la Salud
Language: Español
Tweet
A. Fundamentos de la microbiologia industrial
1. Introducción
2. Bioeconomía
3. Microorganismos e industria
4. Biotecnología, biología sintética y microbiología industrial
B. Crecimiento de microorganismos
5. Cinética del crecimiento microbiano
6. Cultivo discontinuo
7. Cultivo continuo
8. Otros sistemas de crecimiento
C. Ingeniería de bioprocesos
9. Introducción a la ingeniería de bioprocesos
10. Procesos Pre-fermentativos-Upstream Processing
11. Biorreactores
12. Procesos Post-fermentativos-Downstream Processing
D. Fermentaciones industriales
13. Ácidos orgánicos
14. Aminoácidos
15. Biopolímeros
16. Enzimas y proteínas
17. Otros productos
E. Microbiologia industrial alimentaria
18. Cultivos iniciadores (starters)
19. La cerveza
20. El vino
21. Vinagre
22. Productos lácteos
23. Proteína unicelular
F. Microbiología industrial medioambiental
24. Tratamiento de aguas residuales con fangos activos
25. Tratamiento de aguas residuales con biofilms
26. Biorreactores anaerobios
27. Tratamiento de residuos sólidos urbanos y compostaje
28. Bio-refinerías y bio-generación de energía
29. Biominería y Biorremediación
30. Aplicaciones agrícolas
G. Microbiología industrial biosanitaria
31. Antibióticos y antimicrobianos
32. Vacunas
33. Otros productos biosanitarios
34. Ensayos clínicos
Bibliografía
*The digital edition does not include access codes to additional material or programs mentioned in the book.
Este libro no debería existir
Cuando yo hice la carrera, allá por los años 80, una de las cosas que menos me gustaba es que unprofesor “recomendara” su libro dentro de la bibliografía de la asignatura que impartía. La “recomendación” setransformaba en “obligación”, ya que el profesor generalmente usaba su libro como una especie de catecismopara impartir la asignatura y eso era algo que limitaba nuestro conocimiento de la materia. Muchos de esos libros recomendados habían sido escritos cinco o seis años antes, por lo que se estaban quedando obsoletos cuando los utilizábamos. Aunque también tenía una ventaja muy evidente: sabías perfectamente qué debías estudiar paraaprobar. No necesitabas consultar otros libros, ni ampliar conocimientos si no querías, ya que lo que estaba en otras obras era muy poco probable que cayese en el examen.
Desde 1998 imparto la materia de Microbiología Industrial en la UMH, y hasta ahora nunca he recomendado un libro único para la asignatura. Siempre he procurado usar varias fuentes bibliográficas para elaborar mis clases. Además, esta disciplina es muy dinámica y diversa, por lo que cada año hay alguna actualización, desarrollo o descubrimiento que tienes que comentar en el aula. Si añadimos internet a la ecuación, podemos pensar que cualquier libro de texto se queda obsoleto de un curso para el siguiente.
Una forma de evitar esa obsolescencia es no recomendar un solo libro y, por supuesto, usar internet. En todos los cursos he procurado que los alumnos tuvieran previamente las diapositivas que iba a usar en la impartición de las lecciones magistrales para que pudieran recoger apuntes con más facilidad. Y, además, así podía incluir enlaces a webs o artículos para que pudiesen ampliar sus conocimientos. En pocas palabras, tratabade impartir mis clases como a mí me hubiera gustado que me las hubieran impartido.
Pero como dice el refrán, “nunca digas de este agua no beberé...”. El motivo por el cual existe este libro es precisamente por petición del respetable público. Cada año participo en el programa de encuestas de calidad de la docencia de la UMH. Además, en paralelo, suelo realizar unas encuestas propias para conocer lo que piensan los alumnos de la asignatura. En ambas encuestas hay una sección de comentarios para el profesor. Pues bien, todos los años aparecen al menos unos cuantos en los que se pide que el profesor publique sus apuntes para así facilitar el estudio de la asignatura. Y hay otro motivo adicional, gracias a la internet más de un alumno subía sus apuntes de la asignatura a plataformas digitales donde otros alumnos se los podían descargar pagando una cantidad. La verdad es que molesta un poco ver que tus diapositivas originales son “comercializadas” y “comentadas” por otro. Pero es mucho más molesto que un alumno venga a revisar un examen y te diga que lo que ha puesto en una respuesta es correcto por qué es lo que aparece en esos “apuntes tuneados” que se ha bajado.
Así que, tras 20 años de docencia, decidí recopilar todos esos apuntes y publicarlos... en forma de libro. Bueno, más bien en formato e-book, porque tengo claro que la internet es una revolución similar a la de la imprenta, y que una de sus principales ventajas es que siempre puedes actualizarte.
Un último aviso: este es un libro de apuntes y como tal lo mejor es siempre comprobar las fuentes para actualizarse y ampliar la información (y de paso corregir los errores que pueda haber). Además, de vez en cuando he preferido sacrificar la rigurosidad académica y usar un tono desenfadado para explicar ciertos conceptos. Reconozco que la primera edición la escribí un poco deprisa porque quería utilizarla para el curso 2019-20, así que cometí unos cuantos “gazapos”. Muchos de ellos han sido corregidos en esta nueva edición, sobre todo gracias a la labor del profesor Iñigo Fernandez de Larrinoa, del Departamento de Química Aplicada de la Facultad de Química de la UPV/EHU, al que agradezco enormemente su revisión de la primera edición del texto.
Si eres un estudiante, confío en que este libro te ayude a aprobar, pero sobre todo espero que despierte tu curiosidad y amplíes la información que aquí se describe. Si eres un profesor, confío en que puedas encontrarlo útil para tus clases y que seas indulgente con los errores que encuentres. Sí que te agradecería que me los indicases escribiéndome un e-mail (me puedes encontrar en la web de la UMH https://umh.es/contenido/Universidad/:persona_4284/datos_es.html)
Gracias por leerlo.
No notes from the Author
METHODS OF PURCHASE
* Prices with VAT
| (Includes 1 year of digital book rental) |
|---|
| 30,00 € |
Search the term or terms within each of the books